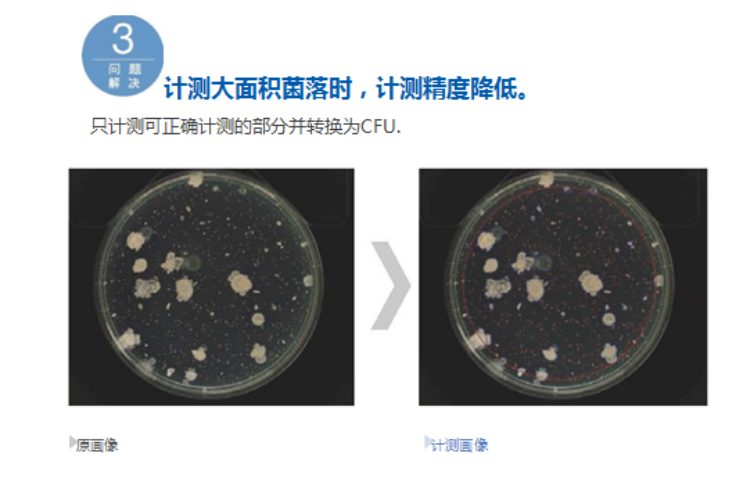
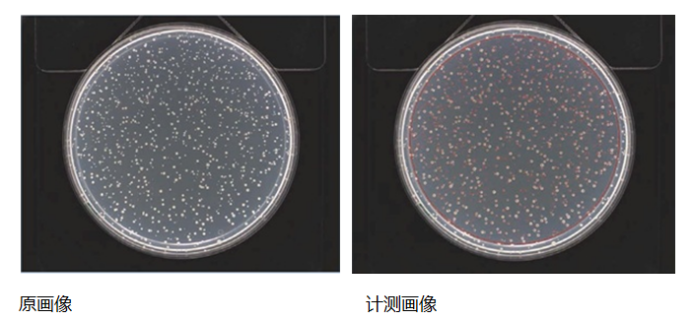

在食品药品安全检测、微生物研究等领域,菌落计数是一项关键且繁琐的工作。传统手动计数不仅耗时费力,还易受人为因素影响,导致数据结果的准确性大打折扣。如今,国初科技凭借其领先的全自动菌落计数器技术,轻松解决行业痛点,重新定义了菌落计数标准。
传统手动菌落计数在面对密集菌落时,工作人员需花费10分钟甚至更久来完成一个样本的计数工作,不仅效率低下,还容易让检测人员产生视觉疲劳,影响计数的准确性。而全自动菌落计数器,依托先进的高速图像处理技术,将这一过程缩短至仅需5秒钟,且根据菌落的数量与种类,计数时间可能会有更优表现。这一巨大的效率提升,使得检测人员能够在更短的时间内完成更多样本的检测,大幅提高了工作效率。
全自动菌落计数器是一种集高分辨率成像、智能图像识别算法和自动化控制技术于一体的微生物分析设备。它能够自动完成培养皿的扫描、菌落识别、数量统计、大小分析、分类归类及数据输出等一系列复杂过程,实现了从“人眼观察”到“机器智能识别”的重大跨越。
全自动菌落计数器采用了多项创新技术,确保计数的精准度。它能够针对每个菌落的面积进行单独测量,通过设定指定的直径,结合培养基厚度固定的条件,利用固定的二值化系数,精准测量指定的菌落。在自动测量过程中,该设备还能自动排除大型菌落,避免对计数结果产生干扰。同时,可测量的区域能够自动计算,并实现精确的CFU(菌落形成单位)转换,为科研和质检工作提供了可靠的数据支持。其工作原理基于先进的光学成像技术和智能图像处理算法。首先,通过专业级彩色或灰度相机,配合均匀光源(如LED漫反射照明),获取培养皿上菌落的清晰图像,确保图像无阴影、无反光。接着,利用深度学习与机器视觉技术,对图像进行精准分析,能够分割粘连菌落、识别微小菌落(低至0.1mm),并区分目标菌与杂菌或杂质。同时,还支持形态学分析,可自动测量菌落的直径、面积、圆度、颜色等参数。最后,通过自动化操作流程,配备自动进样器或多皿扫描平台,可连续处理数十个培养皿,一键启动后自动完成拍照、分析、计数与报告生成,整个过程无需人工干预,大幅提高了工作效率。
全自动菌落计数器的核心优势包括:
-
高效快速提通量:单培养皿分析仅需5-10秒,效率超人工10倍,适配大批量样本检测(如食品微生物筛查),节省时间成本;
-
精准可靠符标准:规避人工漏数、误判,结果重复性高,符合ISO、GB、USP等国际标准,保障制药无菌检查、环境监测数据准确性;
-
智能分类满足需求:可按颜色、大小、形状分类统计菌落,支持混合菌群分析与目标菌筛选(如大肠菌群、金黄色葡萄球菌),助力疾控应急检测;
-
数据可追溯便管理:自动保存原始图像、分析结果及操作日志,支持审计追踪(符合GMP、GLP),数据可导出Excel/PDF,便于科研存档与报告编制;
-
人机友好易操作:配备触摸屏界面,支持自定义分析模板、阈值设置与结果复核,兼顾自动化与人工干预灵活性,降低操作门槛;
全自动菌落计数器的应用场景包括:
-
食品行业:检测菌落总数、大肠菌群等,快速识别污染,保障产品微生物安全;
-
制药企业:用于无菌检查、洁净室沉降菌监测,严控污染,保障药品质量;
-
疾控与检验机构:在突发公共卫生事件(如新冠)中,快速筛查样本,支撑防控决策;
-
科研实验室:采集微生物生态、抗菌实验等数据,助力科研探索;
国初科技始终以技术创新为核心,其全自动菌落计数器凭借高效、精准、便捷的优势,为微生物检测工作提供有力支持,助力行业提升检测水平,保障产品安全与研究质量。
国初科技(厦门)有限公司自成立以来,以膜分离技术为核心,致力于新型分离技术的推广,不断探索新型膜分离技术在电力、化工、生物制药、微电子、冶金、机械、食品、乳品、饮料、环境等领域的新应用。根据不同客户的高度差异化需求,提供针对性的过滤及纯化综合解决方案,提高产品品质,满足客户需求。